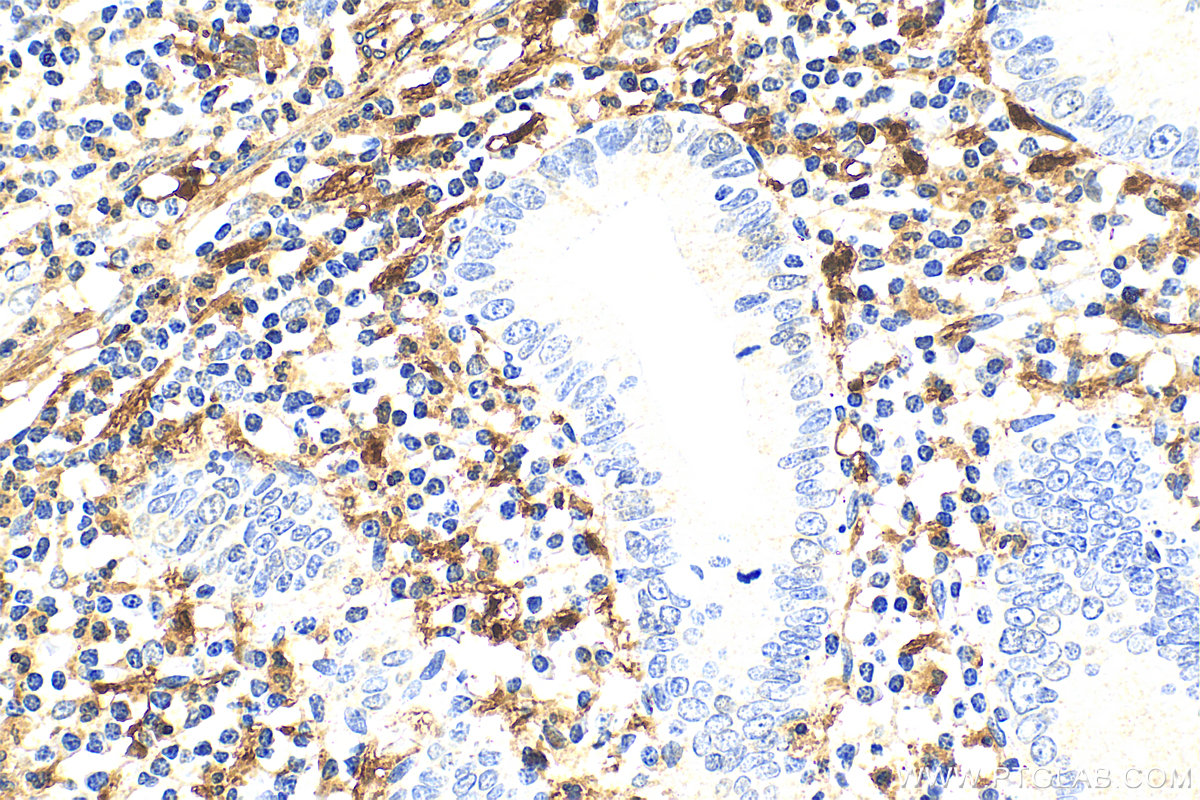
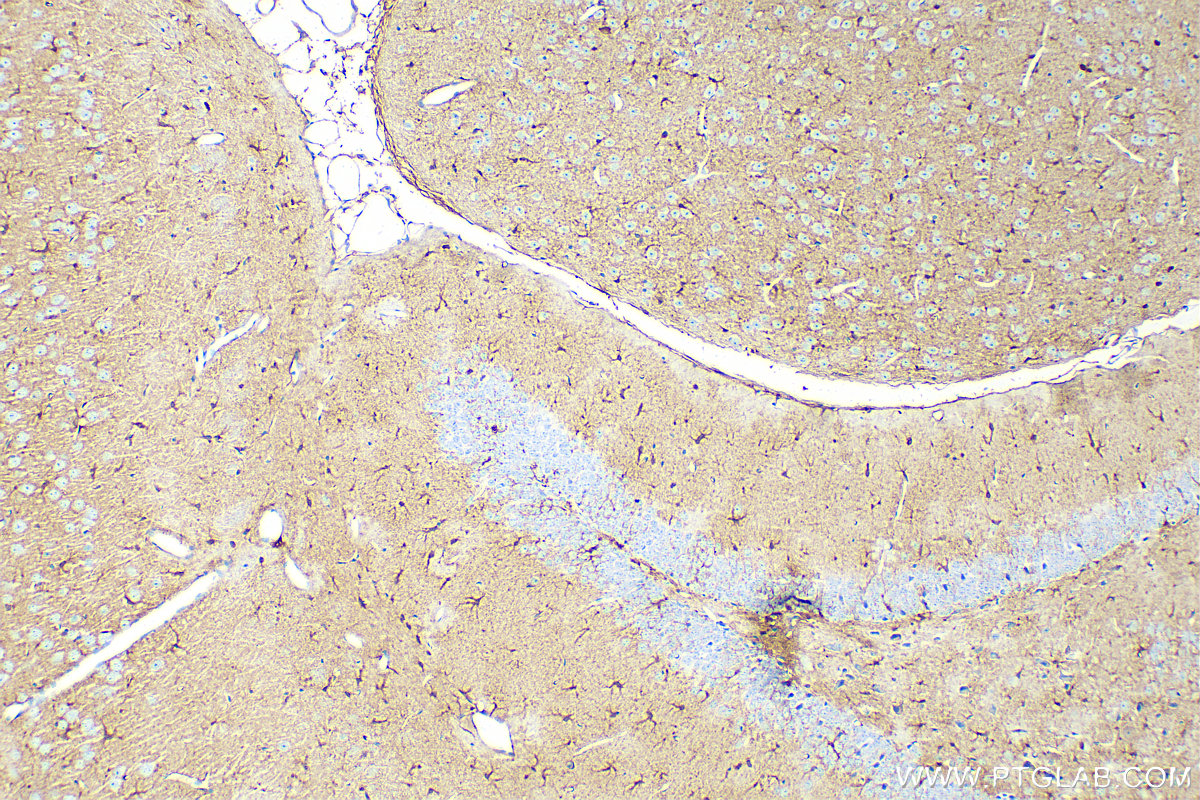

验证数据展示
经过测试的应用
| Positive WB detected in | mouse brain tissue, A375 cells, human testis tissue, U-251 cells, C6 cells, rat brain tissue |
| Positive IHC detected in | human malignant melanoma tissue, human appendicitis tissue, human gliomas tissue, mouse brain tissue, rat brain tissue Note: suggested antigen retrieval with TE buffer pH 9.0; (*) Alternatively, antigen retrieval may be performed with citrate buffer pH 6.0 |
| Positive IF-P detected in | mouse brain tissue, human malignant melanoma tissue, mouse cerebellum tissue, rat brain tissue |
| Positive IF/ICC detected in | human astrocytes, A375 cells |
| Positive FC (Intra) detected in | A375 cells |
推荐稀释比
| 应用 | 推荐稀释比 |
|---|---|
| Western Blot (WB) | WB : 1:4000-1:20000 |
| Immunohistochemistry (IHC) | IHC : 1:1000-1:6000 |
| Immunofluorescence (IF)-P | IF-P : 1:50-1:500 |
| Immunofluorescence (IF)/ICC | IF/ICC : 1:50-1:500 |
| Flow Cytometry (FC) (INTRA) | FC (INTRA) : 0.50 ug per 10^6 cells in a 100 µl suspension |
| It is recommended that this reagent should be titrated in each testing system to obtain optimal results. | |
| Sample-dependent, Check data in validation data gallery. | |
产品信息
15146-1-AP targets S100B in WB, IHC, IF/ICC, IF-P, FC (Intra), ELISA applications and shows reactivity with human, mouse, rat samples.
| 经测试应用 | WB, IHC, IF/ICC, IF-P, FC (Intra), ELISA Application Description |
| 文献引用应用 | WB, IHC, IF, ELISA |
| 经测试反应性 | human, mouse, rat |
| 文献引用反应性 | human, mouse, rat |
| 免疫原 |
CatNo: Ag7440 Product name: Recombinant human S100B protein Source: e coli.-derived, PGEX-4T Tag: GST Domain: 1-92 aa of BC001766 Sequence: MSELEKAMVALIDVFHQYSGREGDKHKLKKSELKELINNELSHFLEEIKEQEVVDKVMETLDNDGDGECDFQEFMAFVAMVTTACHEFFEHE 种属同源性预测 |
| 宿主/亚型 | Rabbit / IgG |
| 抗体类别 | Polyclonal |
| 产品类型 | Antibody |
| 全称 | S100 calcium binding protein B |
| 别名 | S100 beta, Protein S100 B, Protein S100-B, S100 calcium-binding protein B, S-100 protein beta chain |
| 计算分子量 | 11 kDa |
| 观测分子量 | 11 kDa |
| GenBank蛋白编号 | BC001766 |
| 基因名称 | S100 Beta |
| Gene ID (NCBI) | 6285 |
| RRID | AB_2254244 |
| 偶联类型 | Unconjugated |
| 形式 | Liquid |
| 纯化方式 | Antigen affinity purification |
| UNIPROT ID | P04271 |
| 储存缓冲液 | PBS with 0.02% sodium azide and 50% glycerol, pH 7.3. |
| 储存条件 | Store at -20°C. Stable for one year after shipment. Aliquoting is unnecessary for -20oC storage. |
背景介绍
S100B belongs to the EF-hand calcium binding proteins and is found primarily in astrocytes in the central nervous system (CNS). S100B has a variety of functions, including calcium homeostasis, cell proliferation, differentiation, migration, and survival, as well as neurite outgrowth and regeneration.
1. What is the molecular weight of S100B?
S100B protein is composed of non-covalently linked homodimers of 11 kDa size.
2. What is the subcellular localization of S100B?
S100B localizes to the nucleus and cytoplasm, associating with intracellular membranes, the centrosomes, microtubules, and type III intermediate filaments (PMID: 19110011). Additionally, it can be released from astrocytes into the extracellular space and can enter the bloodstream.
3. What is the expression pattern of S100B?
S100B is predominantly expressed in astrocytes and maturing oligodendrocytes but is also present in other cell types such as kidney epithelial cells, neural progenitor cells, pituicytes, ependymocytes, chondrocytes, adipocytes, melanocytes, Langerhans cells, dendritic cells, certain lymphocyte subpopulations, skeletal myofibers, myoblasts, and muscle satellite cells (PMID: 19110011). S100B is a commonly used marker of Schwann cells and reactive astrocytes in ICC, IHC, and WB applications.
4. What is the diagnostic use of S100B in the clinic?
S100B is naturally secreted by astrocytes into the extracellular space and low amounts of S100B can pass through the brain-blood barrier and enter the bloodstream. Elevated levels of S100B in the serum are observed in patients with traumatic head injuries, as well as in patients suffering from neurodegenerative diseases (PMID: 30144068). This increase in S100B levels is attributed to the elevated secretion of S100B protein from astrocytes as part of the physiological response to the injury, as well as to the physical damage of astrocytes and increased blood-brain barrier permeability.
实验方案
| Product Specific Protocols | |
|---|---|
| FC protocol for S100B antibody 15146-1-AP | Download protocol |
| IF protocol for S100B antibody 15146-1-AP | Download protocol |
| IHC protocol for S100B antibody 15146-1-AP | Download protocol |
| WB protocol for S100B antibody 15146-1-AP | Download protocol |
| Standard Protocols | |
|---|---|
| Click here to view our Standard Protocols |
发表文章
| Species | Application | Title |
|---|---|---|
Cell Mechanoreceptor synapses in the brainstem shape the central representation of touch. | ||
Sci Bull (Beijing) Restoring sweat gland function in mice using regenerative sweat gland cells derived from chemically reprogrammed human epidermal keratinocytes | ||
Nat Commun Alk1 acts in non-endothelial VE-cadherin+ perineurial cells to maintain nerve branching during hair homeostasis | ||
Neuron γ-Protocadherins control synapse formation and peripheral branching of touch sensory neurons |